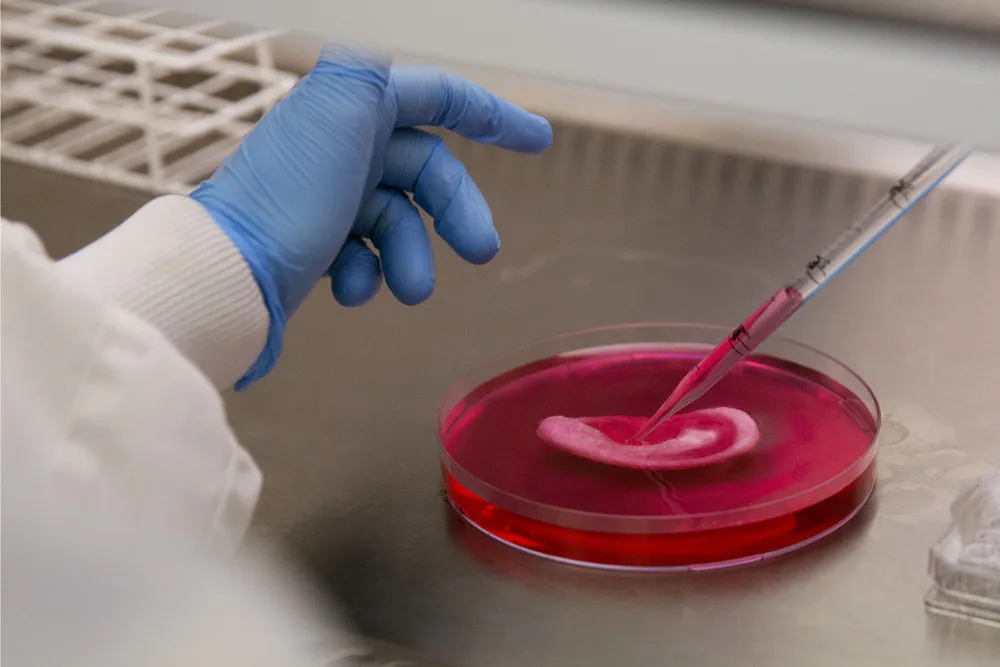
London Hospital Touts Lab-grown Body Parts

|
London Hospital Touts Lab-grown Body Parts
|
||
|
|
||
|
|

|
|
| ← Previous picture Next picture → | ||
|
Military Woman Gallery
Must See Places |
||
|
|
||
|
London Hospital Touts Lab-grown Body Parts
|
||
|
|
||
|
|
|
|
| ← Previous picture Next picture → | ||
|
Military Woman Gallery
Must See Places |
||
|
|
||